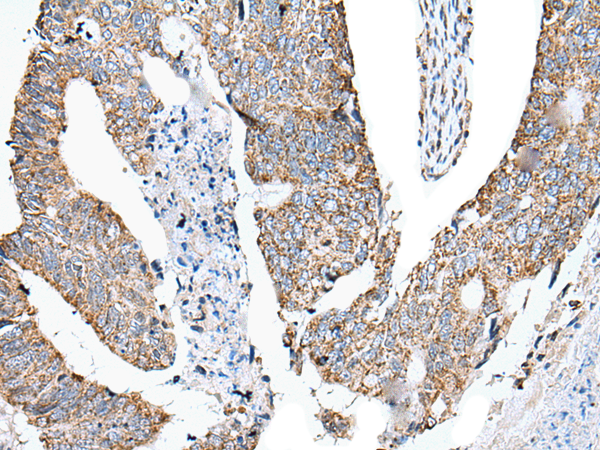

|
Background: |
Defensins form a family of antimicrobial and cytotoxic peptides made by neutrophils. Defensins are short, processed peptide molecules that are classified by structure into three groups: alpha-defensins, beta-defensins and theta-defensins. All beta-defensin genes are densely clustered in four to five syntenic chromosomal regions. Chromosome 8p23 contains at least two copies of the duplicated beta-defensin cluster. This duplication results in two identical copies of defensin, beta 104, DEFB104A and DEFB104B, in head-to-head orientation. This gene, DEFB104A, represents the more centromeric copy. |
|
Applications: |
ELISA, IHC |
|
Name of antibody: |
DEFB104A |
|
Immunogen: |
Synthetic peptide of human DEFB104A |
|
Full name: |
defensin beta 104A |
|
Synonyms: |
BD-4; DEFB4; hBD-4; DEFB-4; DEFB104 |
|
SwissProt: |
Q8WTQ1 |
|
ELISA Recommended dilution: |
5000-10000 |
|
IHC positive control: |
Human colorectal cancer and human esophagus cancer |
|
IHC Recommend dilution: |
25-100 |

購物車
購物車 幫助
幫助
 021-54845833/15800441009
021-54845833/15800441009
